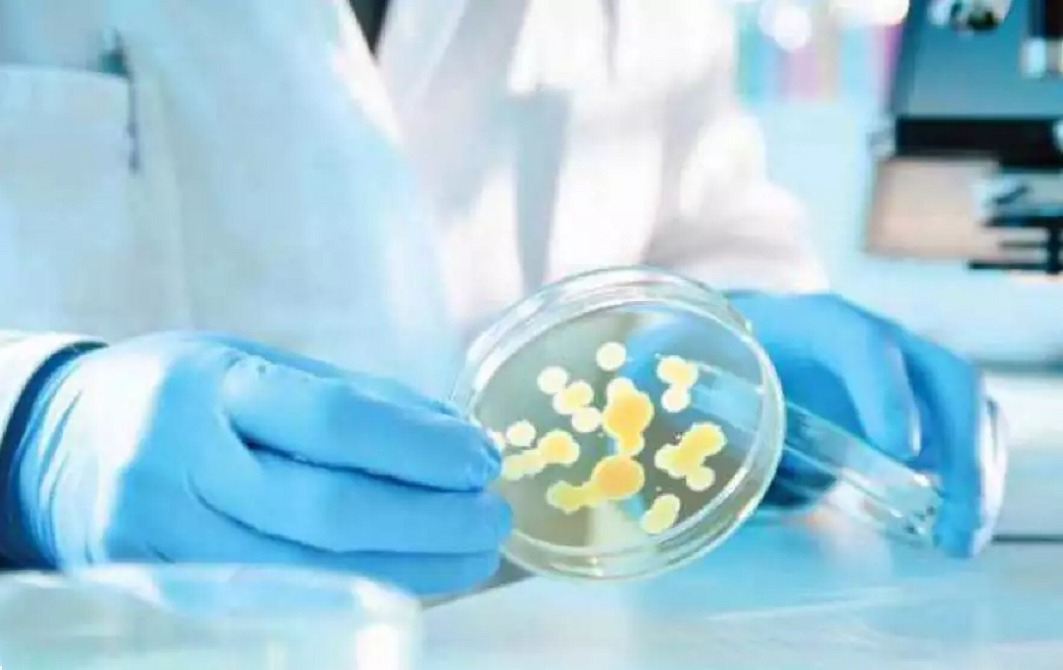

15 січня, з Надвірнянського районного відділу ДУ «ІФОЦКПХ МОЗУ» отримали повідомлення про випадок групового захворювання 19 дітей, які проживали в приватній садибі смт. Ворохта, Надвірнянського району, Івано-Франківської області.
Про це Фіртці повідомили в головному управлінні Держпродспоживслужби в області.
Відпочинкова група із м. Кропивницький 12.01.2023 о 11:00 год. в кількості 52 осіб, в тому числі 45 дітей та 7 дорослих, прибули на відпочинок в приватну садибу «Скита» смт. Ворохта, Надвірнянського району, Івано-Франківської області. Група проживала та харчувалася в даній приватній садибі.
13 січня в другій половині дня частина дітей відчули погіршення самопочуття, а саме: скаржились на загальну слабкість, нудоту, блювоту, біль в животі, підвищення температури тіла до 37,5-38 С0 та пронос до 4-6 разів на добу.
14 дітей були госпіталізовані до Надвірнянської дитячої лікарні та 5 дітей до інфекційного відділу Надвірнянської ЦРЛ з попереднім діагнозом «Гострий гастроентероколіт, ентероколіт». Стан хворих у 5-ти осіб –середнього ступеня важкості та у 14- легкого ступеня важкості.
читайте також: Четверо прикарпатців отруїлися грибами, двоє із них — діти. Поради, як вберегтись
15 січня спеціалістами Яремчанського відділу Надвірнянського районного управління Головного управління Держпродспоживслужби в Івано-Франківській області розпочато проведення санітарно-епідеміологічного розслідування даного спалаху по місцю перебування хворих та позаплановий захід державного нагляду (контролю) у сфері безпечності харчових продуктів в приватній садибі «Скита» смт. Ворохта Надвірнянського району Івано-Франківської області.
Для лабораторного дослідження відібрано 30 змивів на патфлору з об’єктів навколишнього середовища та 1 пробу води питної для мікробіологічного та санітарно-хімічного дослідження.
Станом на 10:00 год 16 січня року всі хворі діти виписані з лікарні.
"Водночас, наголошуємо керівникам дитячих груп, які планують здійснювати відпочинок дітей в приватних закладах, перевірити чи обраний заклад зареєстрований як оператор ринку харчових продуктів та внесений в державний реєстр закладів оздоровлення та відпочинку дітей.
Керівникам приватних садиб, які планують здійснювати відпочинок організованих груп дітей, необхідно звернутися до територіального відділу/управління Головного управління Держпродспоживслужби в Івано-Франківській області для здійснення безпечного відпочинку дітей", - йдеться в дописі.
Підписуйтесь на канал Фіртки в Telegram, читайте нас у Facebook, дивіться на YouTubе. Цікаві та актуальні новини з першоджерел!
Читайте також:
На Коломийщині двоє людей отруїлися чадним газом, серед постраждалих - дитина
Отруїлися чадним газом: у Бурштинській ТГ виявили тіла двох загиблих
У Тлумачі троє дорослих та дитина отруїлися чадним газом
Харчові отруєння на Прикарпатті: які причини, як їх уникнути та профілактика інфекцій
























